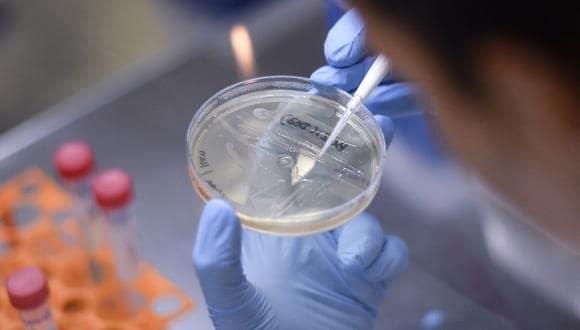
Delta: carga viral mil veces mayor a otras mutaciones Covid Delta: carga viral mil veces mayor a otras mutaciones Covid

Sabias Que Cultural
Delta: carga viral mil veces mayor a otras mutaciones Covid
Publicación:24-07-2021
TEMA: #Cultura
La Organización Mundial de la Salud (OMS) notificó que ya se encontraba en 92 países, 14 de ellos de Latinoamérica, incluido México
CIUDAD DE MÉXICO.- Un nuevo estudio reveló que la gravedad de Delta, una de las variantes de preocupación (VOC) del Covid-19
, tiene que ver con la carga viral que produce en quienes se infectan con ella, que es mil veces mayor que la desencadenada por las mutaciones convencionales.
Esta variante se ha convertido en el mayor obstáculo para superar la pandemia actual. Desde su identificación en la India, en octubre de 2020, la comunidad científica comenzó a observarla de cerca, ya que a diferencia de otras mutaciones, Delta es mucho más transmisible.
¿Qué quiere decir esto? Cuando una persona contrae a Delta produce muchos más virus. Es por ello que se ha convertido en la responsable de la mayoría de nuevos casos del SARS-CoV-2, alrededor del mundo.
Hasta inicios de este mes, la Organización Mundial de la Salud (OMS) notificó que ya se encontraba en 92 países, 14 de ellos de Latinoamérica, incluido México.
La investigación, liderada por Jing Lu, epidemiólogo del Centro Provincial de Control y Prevención de Enfermedades de Guangdong, en China, analizó a 62 personas infectadas con esta variante.
El equipo evaluó la "carga viral" desarrollada por las y los participantes. Diariamente, registraron la densidad de las partículas virales generadas en el cuerpo, con el objetivo de conocer el curso y los cambios que atravesaba la infección con el paso de los días.
Más tarde, los investigadores compararon los patrones de infección de los participantes con los de 63 personas que contrajeron la cepa original del SARS-CoV-2, durante el 2020.
Los resultados, publicados en "medRxiv", mostraron que la variante Delta comienza a manifestarse luego de los cuatro días de la exposición con otra persona infectada. A diferencia lo que ocurre con la variante convencional, que se visibiliza después de seis días.
Según los expertos esto comprueba la rapidez con la que se replica la variante. Además, descubrieron que las personas infectadas con Delta tenían cargas virales de hasta mil 260 veces más altas.
Benjamin Cowling, epidemiólogo de la Universidad de Hong Kong, señaló que la combinación de una gran cantidad de virus y un corto período de incubación tiene sentido como explicación de la elevada transmisibilidad de Delta.
"La gran cantidad de virus en el tracto respiratorio significa que es probable que los eventos de súper propagación infecten incluso a más personas, y que las personas pueden comenzar a propagar el virus antes de infectarse", profundizó.
Sin embargo, los investigadores reconocieron que estos resultados no son los definitivos y que, a medida que los estudios en torno a Delta prosigan -en diferentes regiones-, las estimaciones de la carga viral se modificarán.
En este contexto, los especialistas coincidieron en que aún son muchas las preguntas sobre la variante Delta que siguen sin respuesta.
Una de ellas -y de las más preocupantes- tiene que ver con que si aumenta la gravedad de las infecciones y si tiene la capacidad de evadir los anticuerpos producidos por las vacunas o por la misma enfermedad.
"Este virus nos ha sorprendido", reconocieron.
Esta variante se ha convertido en el mayor obstáculo para superar la pandemia actual. Desde su identificación en la India, en octubre de 2020, la comunidad científica comenzó a observarla de cerca, ya que a diferencia de otras mutaciones, Delta es mucho más transmisible.
¿Qué quiere decir esto? Cuando una persona contrae a Delta produce muchos más virus. Es por ello que se ha convertido en la responsable de la mayoría de nuevos casos del SARS-CoV-2, alrededor del mundo.
Hasta inicios de este mes, la Organización Mundial de la Salud (OMS) notificó que ya se encontraba en 92 países, 14 de ellos de Latinoamérica, incluido México.
La investigación, liderada por Jing Lu, epidemiólogo del Centro Provincial de Control y Prevención de Enfermedades de Guangdong, en China, analizó a 62 personas infectadas con esta variante.
El equipo evaluó la "carga viral" desarrollada por las y los participantes. Diariamente, registraron la densidad de las partículas virales generadas en el cuerpo, con el objetivo de conocer el curso y los cambios que atravesaba la infección con el paso de los días.
Más tarde, los investigadores compararon los patrones de infección de los participantes con los de 63 personas que contrajeron la cepa original del SARS-CoV-2, durante el 2020.
Los resultados, publicados en "medRxiv", mostraron que la variante Delta comienza a manifestarse luego de los cuatro días de la exposición con otra persona infectada. A diferencia lo que ocurre con la variante convencional, que se visibiliza después de seis días.
Según los expertos esto comprueba la rapidez con la que se replica la variante. Además, descubrieron que las personas infectadas con Delta tenían cargas virales de hasta mil 260 veces más altas.
Benjamin Cowling, epidemiólogo de la Universidad de Hong Kong, señaló que la combinación de una gran cantidad de virus y un corto período de incubación tiene sentido como explicación de la elevada transmisibilidad de Delta.
"La gran cantidad de virus en el tracto respiratorio significa que es probable que los eventos de súper propagación infecten incluso a más personas, y que las personas pueden comenzar a propagar el virus antes de infectarse", profundizó.
Sin embargo, los investigadores reconocieron que estos resultados no son los definitivos y que, a medida que los estudios en torno a Delta prosigan -en diferentes regiones-, las estimaciones de la carga viral se modificarán.
En este contexto, los especialistas coincidieron en que aún son muchas las preguntas sobre la variante Delta que siguen sin respuesta.
Una de ellas -y de las más preocupantes- tiene que ver con que si aumenta la gravedad de las infecciones y si tiene la capacidad de evadir los anticuerpos producidos por las vacunas o por la misma enfermedad.
"Este virus nos ha sorprendido", reconocieron.
« El Universal »
Te podria interesar
Otras Noticias








